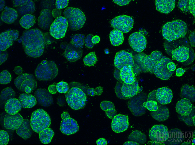
微信截图_20200811141504.png

“只有一个记忆卡大小的人体器官微缩模型,可以使研究人员用前所未有的方式检验生物机制和行为、检验过程、控制过程,为医学和药物制造带来彻底的变革。”2016年世界达沃斯经济论坛上,器官芯片被评为十大新兴技术之一,成为与区块链、纳米传感器、石墨烯等新兴技术并列的十大创新技术。于生物医药领域而言,器官芯片将极有可能成为又一颠覆性前沿技术,为生物医药研发难题提供解决方案。
器官芯片应运而生。麦姆斯咨询研究分析,器官芯片有潜力为生理相关的体外药物测试提供更好的试验预测。每年可节省数亿美元的开发成本,缩短药物开发时间,并能避免由于2D细胞培养和动物实验等替代模型缺乏预测性而导致的失败。
生物组织工程和微流控技术的结合,使三维人体器官生理微系统,如活体细胞、组织界面、生物流体、机械力等器官“微环境”关键要素得以在这一块方寸之间的器官芯片上构建。人类器官结构和功能特征也由此实现在人体外的重现。
基于这块芯片,呼吸的“肺”、跳动的“心脏”、流动的“血管”……开始剥离开与人类具有种属差异的动物体独立于人体外而存在。器官芯片将为实验精准度以及研发进程带来大幅提升。
事实上当2010年器官芯片的概念刚传入国内,大橡科技核心人员便开始对这一领域进行研究学习。十多年的研究经历,使得其核心人员兼具微流控芯片技术及细胞组织工程学的专业见解。其中,大橡科技CTO肖荣荣研究内容便横跨生物技术、微流控芯片、生物组织工程、分子生物学在内的多个专业领域。
核心技术的研发能力成为了大橡科技得以在仍处于萌芽期的器官芯片市场中,成为佼佼者的一大原因。
目前,大橡科技已研发出三款器官芯片平台,并在此基础上构建了肿瘤、肝、血脑屏障、肝-肿瘤、血脑屏障-肿瘤等多种器官芯片模型,实现了细胞从2D维度向3D维度的跨越。
可能与不可能:器官芯片的前世今生
2004年,全球第一篇关于器官芯片的研究文章发表,提出了这一概念。2010年,在中美两国器官芯片研究仍基本处于同一起跑线时,美国政府开始有组织、系统性的支持器官芯片研究及后续产业化,对器官芯片研发投入了大量资源。
尽管中国的科研机构在2010年前后也开始投入更多精力研究器官芯片技术,科技部也在2013年推出器官芯片重大专项。但器官芯片行业在国内整体仍缺乏资金和政府系统性组织的支持,停留在科研层面,多是科研性文章产出,产业应用极少,行业发展相对落后。
相较于国内以动物模型使用为主的新药临床前试验,欧美药企由于对试验精准度、研发回报率的追求,使其持续加大在器官芯片研究使用上的投入。器官芯片已逐渐成为其减少动物实验、推动新药研发的重要工具。
过去,国内药企以研制仿制药为主,对临床前试验数据要求不高,导致国内器官芯片应用场景较为缺乏。2017年起,中国创新药产业政策支持力度加大,多项政策的发布,使国内创新药研发迈入黄金期,自主可控的生物医药研发成为国家战略性发展需求。
多年在行业内的沉淀,使大橡科技敏锐的察觉到了这一市场痛点,选择在器官芯片领域作出深入的布局,聚集了一批通识微流控、医学组织工程、细胞生物学、药理学、病理学等学科“专才”,用核心研发能力打破了不可能,推出国内首款商用器官芯片平台IBAC S1、IBAC M1、IBAC M2及其他器官芯片模型。以降低新药研发成本、缩短新药研发周期、降低新药研发的失败几率。
IBAC S:科研福音
针对科研用户,大橡科技专门研发了片IBAC S系列器官芯片。这一类芯片为3D单器官芯,相较于市场上低吸附U型培养板,该类芯片大小孔嵌套设计使每一小孔仅需1-10μL凝胶。防蒸发设计更是解决了试验边缘效应的问题,降低了新药研发产品用量。其96孔的设计,则使试验能够进行高通量药物筛选。
同时,该器官芯片拥有对细胞微环境极强的仿生能力,能够适用基于各类水凝胶的细胞3D培养。其与高内涵仪器兼容,成像试验可精准定位。超薄光学透明玻璃底板,则为更高质量的成像打下基础。在器官芯片的材料上,大橡科技选用黑色材料解决了荧光信号串扰问题。
目前,大橡科技已应用IBAC S1/SR1构建了3D肿瘤模型、3D PHH肝毒模型,并完成了类器官培养、血管生成等实验。
IBAC M1:以多器官芯片构建具屏障功能器官模型
IBAC M系列主打多器官芯片,IBAC M1这一款屏障类器官芯片平台,能够通过重力作用驱动流体流动,实现高通量、无泵、连续恒定灌流。该款器官芯片不仅具有IBAC S系列功能,还能够与商品化跨膜电阻测量仪兼容,快速、实时监测屏障。基于IBAC M1可构建各种具有屏障功能的单器官模型,如血脑屏障、肠、肾、肺等,也可以构建具有屏障功能的多器官共培养模型,如BBB-肿瘤模型,肠-脑模型等。
IBAC M2:以耦合型设计打造易用研发工具
IBAC M2是大橡科技研发生产的耦合型多器官芯片,其上下耦合型芯片设计,使该芯片可以实现灵活组装和拆卸。上层芯片十字形设计,可以实现3D器官的微量、高效固定。下层芯片的通道设计,使换液和加药无需拆卸芯片,更为简便易用。基于IBAC M2,可构建非屏障功能的多器官共培养模型,如肝-肿瘤模型等。
大橡科技三款产品的问世,满足了药物研发所需多维度要求,也补足了国内器官芯片商用的市场空白,缓解了国外相关公司对中国技术“卡位”的潜在风险,为国内药企新药研发提供了更有竞争力的创新技术和平台。国产器官芯片问世对推进国内生物医药行业新药研发进程具有重要意义。

未来可期:多类别器官芯片赋能新药研发
众所周知,从概念设计到产品上市,创新药的研发周期甚至可能是一场长达10余年的长跑。但在这场漫长的奔袭中,新药研发的回报率是广受生物制药公司关注的重要一环。据德勤研究报告显示,2019年大型生物制药公司新药研发回报率水平已至9年新低,仅为1.9%。对于制药公司而言,高强度的研发投入未必能够带来较高的回报。
“我们希望用器官芯片技术构建一个健康的世界,赋能新药研发以及个体化精准用药。通过降低药物研发周期成本及研发失败几率,最终造福患者。”大橡科技创始人周宇告诉动脉网。正是这样一颗初心,使大橡科技敢于迈入这一新兴领域,为新药研发提供更多解决方案。
“器官芯片”、“类器官芯片”是大橡科技目前所拥有的两项核心技术,目前大橡科技正在针对“一站式流控培养系统”进行持续研究。
“仿生性确实能够提高试验精准度,但一味的追求只会使器官芯片操作难度增大、通量降低,显得华而不实。我们要解决这个问题,找到平衡点。”周宇说道。不同于海外器官芯片技术,大橡科技所产器官芯片并不一味追求仿生性,而是不断寻找仿生与通量之间的平衡点,使器官芯片效用最大化。大橡科技针对药企的研发需求,提供高仿生、微量、高通量、高效的器官芯片产品。

大橡科技器官芯片技术主要特点
同时,大橡科技利用类器官和器官芯片的技术优势,形成类器官芯片平台,通过提高器官芯片技术中心细胞来源层面的仿生性,实现类器官与器官芯片技术优势互补。其中,类器官芯片平台具有以下优势:
1.流体通道设计,解决传统静态培养方式中营养代谢障碍问题和力生物学信号模拟,提高类器官培养成功率。
2.芯片小型化,节省类器官和耗材的成本。
3.微小培养体系中分泌因子更易累计达到较高浓度,以实现少量样本培养、降低培养周期并提高试验效率。
4.芯片采用非PDMS材料,减少小分子药物的非特异性吸附。
5.稳定性及重现性,减少尺寸、结构、功能以及基因表达之间的差异。
6.芯片易用性设计,降低操作难度以及人为操作引入的结果变异。
7.实现从类器官培养到高通量药敏测试的一站式芯片解决方案。
目前,大橡科技聚焦于肿瘤、肝、屏障类器官芯片的研发。
同时,大橡科技将以三个器官芯片平台为基础,进一步扩展肠道、肾脏、肺脏、非酒精性肝炎等相关的病理、生理模型以及创新的类器官芯片模型(目前已构建肿瘤、肝、血脑屏障、肝-肿瘤、血脑屏障-肿瘤等多种病生理模型)。
肿瘤模型-IBAC Tumor
大橡科技器官芯片沿人类疾病演进方向,针对医学界尚未攻克或难以攻克的人体疾病所需体外模型进行相关研究。此次推出的产品,可以说为公司后续产品研发提供了更多数据与经验,使公司有能力产出兼顾仿生与通量特性、满足药物研发需求的器官芯片模型,并成为“临床0期”的标准化技术工具和平台。
尽管未来器官芯片发展过程中还将面临许多需要解决的问题,譬如在仿生的生理模型的基础上,如何更好的实现病理模型的构建?如何真正实现多器官连接和互作,使其具有接近人体系统生物学的功能?产品的标准化、易用性、重现性等等,但大橡科技显然已经打开了国产器官芯片这扇大门。
未来,大橡科技还将继续探索器官芯片的更多可能性,用数字化手段再现生命和疾病过程,在实现精准医疗的同时,提高新药研发的效率和成功率,降低新药研发的成本。
作者:张彩妮